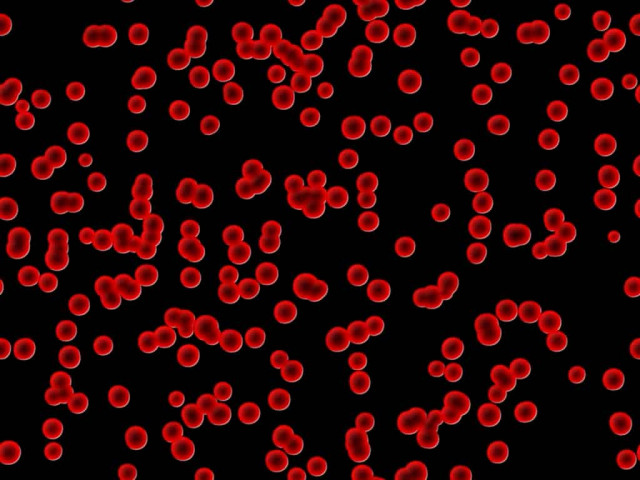
Молодая кровь не делает моложе

Уряд РФ готується до падіння експорту нафти до Індії на 30% та дефіциту бюджету
Уряд РФ готується до падіння експорту нафти до Індії на 30% та дефіциту бюджету
 Саміт на Алясці став "великою аферою" Путіна, - WSJ
Саміт на Алясці став "великою аферою" Путіна, - WSJ
 Моді відмовився зупинити імпорт російської нафти, - Bloomberg
Моді відмовився зупинити імпорт російської нафти, - Bloomberg
 Індія зухвало відмовила Трампу, нагадавши про торгівлю США і РФ
Індія зухвало відмовила Трампу, нагадавши про торгівлю США і РФ
 "Дедлайн" Трампа для Кремля може пройти тихо і без наслідків, - AP
"Дедлайн" Трампа для Кремля може пройти тихо і без наслідків, - AP
 Збільшення видобутку ОПЕК+ та нові погрози Трампа тиснуть на ціни на нафту
Збільшення видобутку ОПЕК+ та нові погрози Трампа тиснуть на ціни на нафту
 На лінії фронту в Україні зона ураження стає дедалі глибшою: в The Economist назвали причини
На лінії фронту в Україні зона ураження стає дедалі глибшою: в The Economist назвали причини
 У російському Брянську пролунали потужні вибухи в районі аеропорту
У російському Брянську пролунали потужні вибухи в районі аеропорту
 Трампу імпічмент, Венсу – посаду: Маск продовжує підливати масла у вогонь
Трампу імпічмент, Венсу – посаду: Маск продовжує підливати масла у вогонь
 Росія масовано атакувала Україну дронами і ракетами: є руйнування і постраждалі
Росія масовано атакувала Україну дронами і ракетами: є руйнування і постраждалі
 Нічний удар Росії по Україні: жителі деяких міст залишилися без світла
Нічний удар Росії по Україні: жителі деяких міст залишилися без світла
 Росія планує у 2026 році захопити дві області та відрізати Україну від Чорного моря, - ОП
Росія планує у 2026 році захопити дві області та відрізати Україну від Чорного моря, - ОП
 У США закликали видворити Маска з країни після сварки з Трампом, - The Hill
У США закликали видворити Маска з країни після сварки з Трампом, - The Hill
 Низка поїздів спізнюється через наслідки атаки на Київ
Низка поїздів спізнюється через наслідки атаки на Київ
 Під час нічного удару росіян у Києві загинули рятувальники
Під час нічного удару росіян у Києві загинули рятувальники
 Порошенко залишив собі слона і причіп, а всі дохідні активи намагався переписати на дружину, - ЗМІ
Порошенко залишив собі слона і причіп, а всі дохідні активи намагався переписати на дружину, - ЗМІ
 В Україні з'явиться військовий омбудсмен: Рада зробила перший крок
В Україні з'явиться військовий омбудсмен: Рада зробила перший крок
 Унікальна спецоперація: СБУ втретє вразила Кримський міст
Унікальна спецоперація: СБУ втретє вразила Кримський міст
 Британія готова судитися з Абрамовичем, щоб передати Україні гроші із продажу "Челсі"
Британія готова судитися з Абрамовичем, щоб передати Україні гроші із продажу "Челсі"
 Ключовий союзник Трампа підтримав законопроект про пекельні санкції проти РФ
Ключовий союзник Трампа підтримав законопроект про пекельні санкції проти РФ
 Росіяни зберігають можливості для масованих авіаударів, але тепер вони обмежені, - експерт
Росіяни зберігають можливості для масованих авіаударів, але тепер вони обмежені, - експерт
 Олена Тополя відверто зізналася, що робила пластику грудей
Олена Тополя відверто зізналася, що робила пластику грудей
 Як рясні дощі вплинуть на врожай картоплі в Україні: відповідь фермера
Як рясні дощі вплинуть на врожай картоплі в Україні: відповідь фермера
 "Це не просто епізод": Шмигаль заявив, що "Павутина" може повторитись
"Це не просто епізод": Шмигаль заявив, що "Павутина" може повторитись
 Генштаб відзвітував про знищення 12 російських літаків
Генштаб відзвітував про знищення 12 російських літаків
Одна из причин старения заключается не в том, что из крови с возрастом исчезают некие «молекулы молодости», а в том, что в ней накапливаются «молекулы старости».
История с молодой кровью началась ещё в 2005 году, когда сотрудники Стэнфордского университета Ирина и Майкл Конбой (Irina Conboy и Michael Conboy) опубликовали в Nature статью, в которой утверждали, что если кровь молодых крыс прокачать через организм старых, то последние в буквальном смысле станут моложе: из их мышц и печени уйдут молекулярные признаки старения, а мышечные стволовые клетки начнут активнее делиться, восстанавливая возрастные клеточные потери; то же самое происходило и с кожей. Всё выглядело так, как будто старение действительно удалось повернуть вспять, и что сделать это удалось именно за счёт молодой крови.
Но кровь – субстанция очень сложная, с огромным числом клеток, белков и прочих биомолекул. Логично было предположить, что в молодой крови есть какое-то вещество, которое препятствует старению, и что в старой крови такого вещества нет. Его начали активно искать.
Два года назад исследователи из Гарварда повторили «кровавый» эксперимент и обнаружили, что омоложению поддаются не только обычные, скелетные мышцы, но и сердце; более того, они сообщили о том, что им удалось найти молекулярное «молодильное яблоко» – им якобы оказался белок под названием GDF-11, фактор тканевой дифференцировки 11. GDF-11 не только омолаживал сердце и скелетные мышцы, но ещё и стимулировал нейрогенез и развитие сосудов в мозге у старых мышей.
Подробнее см.: http://www.nkj.ru/news/30004/ (Наука и жизнь, Молодая кровь не делает моложе)Однако немногим ранее как раз насчёт GDF-11 удалось также выяснить, что он не ускоряет регенерацию тканей, а, наоборот, тормозит её, и с этого момента всё начало запутываться. Когда свойства «молодильного белка» стали перепроверять, то оказалось, что с возрастом его количество не только не уменьшается, а даже растёт (хотя по идее должно было быть наоборот), а когда его в чистом виде вводили старым животным, никакой мышечной регенерации не происходило; более того, мышцы даже медленнее восстанавливались после повреждений – что логично, если принять, что GDF-11 подавляет, а не стимулирует регенерацию.
В прошлом году мы писали о том, какая дискуссиях возникла между сторонниками и противниками омолаживающего белка. Однако дело, по-видимому, вообще не в нём. Только что в Nature Communications вышла статья тех же Ирины и Майкла Конбой, которые вместе с коллегами из Калифорнийского университета в Беркли решили перепроверить свои результаты более чем десятилетней давности.
По их собственному признанию, им не давал покоя метод, который они использовали для «кровавого омоложения» – когда кровеносная система животных хирургическим путём сшиваются в одну. Метод называется гетерохронным парабиозом (гетерохронный – потому что объединяются кровеносные системы разновозрастных индивидуумов), и изобрели его около полутора сотен лет назад. Как легко понять, кровь при парабиозе не переливается, а перемешивается, и невозможно определить, например, какое количество молодой крови нужно для омолаживающего эффекта.
Кроме того, такой эксперимент длится очень долго, и нельзя исключать, что органы животных будут приспосабливаться друг к другу и влиять друг на друга – ведь можно представить, что старый организм становится моложе благодаря молодым почкам, печени, лёгким и пр., с которыми он, старый, временно связан.
Исследователи модифицировали метод парабиоза так, чтобы обмен кровью можно было произвольно включать и выключать, так чтобы это был именно обмен, а не смешивание. По словам авторов работы, новый способ позволял точно отслеживать объём обмениваемой крови и, кроме того, у внутренних органов теперь не было времени на то, чтобы как-то повлиять или привыкнуть друг к другу.
Старым и молодым мышам аккуратно заменили половину всей крови, после чего проверили тех и других на самые разные признаки старения: изменялось ли как-то самочувствие тканей печени и мышц, как работали стволовые клетки, как развивались новые нейроны в мозговых центрах обучения и памяти. Оказалось, что у старых мышей эффекта от молодой крови либо вообще нет, либо он очень слабый – признаки старения уменьшались, но незначительно.
А вот молодые мыши в то же время стремительно старели – например, у них по сравнению с теми, кому никакой старой крови не давали, более чем в два раза замедлялось созревание новых нервных клеток; возрастные признаки проявлялись и в других тканях и органах.
В свете новых данных получается, что старение начинается не из-за того, что из крови – то есть из организма – исчезают некие «молекулы молодости», а потому, что со временем в организме накапливаются «молекулы старости», которые подавляют рост и развитие стволовых клеток, плохо влияют на функционирование органов и т. д.
Омоложение в опытах с парабиозом происходило оттого, что такие «молекулы старости» очень сильно разбавлялись (при парабиозе, как мы сказали, кровь от двух животных перемешивается) и их состаривающий эффект слабел – органы и ткани как бы получали второй шанс.
В целом очень характерный пример того, как важно в науке точно понимать, что мы видим, используя конкретный исследовательский метод, а чего не видим, и как важно перепроверять результаты, особенно, когда они потом начинают вызывать сомнения. Что же до практических результатов, то остаётся надеяться, что в скором времени удастся узнать, что же это за соединения накапливаются в крови с возрастом и можно ли от них как-то избавиться.